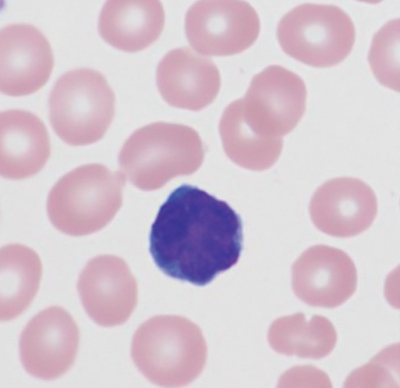
#

60歳の女性。1か月前から37℃台の微熱があり、1週間前に頸部のしこりに気付いた。2日前から背部、前胸部に紅斑が出現し、38℃台の発熱、倦怠感が強くなり、食事摂取もできなくなったため家族に連れられて来院した。
家族歴は、母親が血液疾患のため 60 歳で死亡。末梢血塗抹 May-Giemsa 染色標本を別に示す。
この患者が有していると考えられる疾患の原因ウイルスについて正しいのはどれか。2つ選べ。
a. 抗ウイルス薬が有効である。
b. 母乳感染によることが多い。
c. 献血で発見されることがある。
d. 妊娠中に感染すると児に聴力低下を高率に起こす。
e. 妊娠中に感染が判明したら、出産後にガンマグロブリン注射を行う。